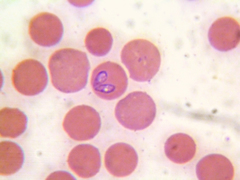
Babesia canis

Babesia canis: taxon details and analytics
- Domain
- Kingdom
- Chromista
- Phylum
- Bigyra
- Class
- Labyrinthulea
- Order
- Piroplasmida
- Family
- Babesiidae
- Genus
- Babesia
- Species
- Babesia canis
- Scientific Name
- Babesia canis
Babesia canis in languages:
- English
- Biliary Fever